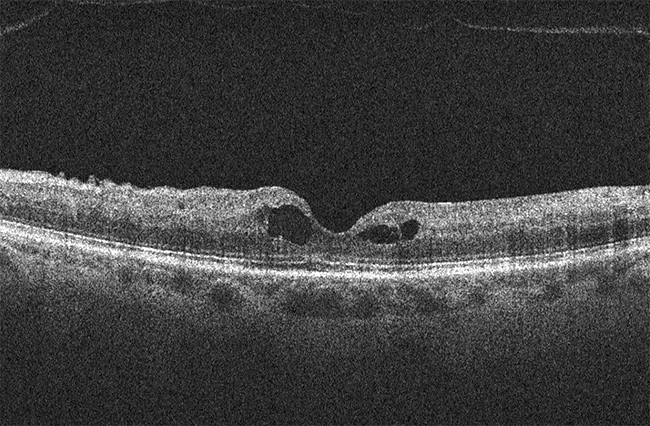

Ineens zag ik niets meer met mijn linkeroog. Het bleek dat ik een oogtrombose had. Een bloedvat achter mijn oog was gesprongen. Heb ik weer!
Ik krijg nu zo’n twee jaar om de 6 a 8 weken weken een ooginjectie. Niet leuk, maar het idee is erger dan de injectie zelf. Gewoon er niet teveel bij nadenken. Als de betreffende oogarts even de tijd neemt en je op je gemakt stelt, dan is het zo gepiept. Soms heb je daarna nog een dag of wat een beetje last van een prikkend en rood oog, maar daar is over heen te komen. Het hangt er wel van af wie de injectie geeft en vooral hoe die wordt gegeven. Mijn ervaring is dat als je als patiënt relaxed bent, de arts beter zijn/haar werk kan doen.
Ooit kreeg ik een bijzonder naar borstonderzoek. De arts was echter heel vriendelijk en legde alles goed uit. Ze zei dat ik mijn hand maar moest opsteken als het pijn deed of het heel naar vond. Dat is heel geruststellend, je weet dat er rekening met je wordt gehouden. Ik heb mijn hand niet op hoeven te steken.
Onlangs had ik een andere oogarts die de oog injectie gaf. Hij was kortaf, bijna snauwerig. Terwijl de voorbereidingen werden getroffen, praatte hij met de assistente over sportauto’s. Dat voelt niet echt lekker. Je hebt het idee dat je bijzaak bent. Toen er een oogspanner, een soort ‘klemmetje’ om je oog open te houden, werd geplaatst, zei hij bits dat ik niet moest knipperen. Nou, ik kan je verzekeren: dan ga je dus juist knipperen!
Hij zette de spanner toen vrij hardhandig op mijn oog, wat ik ondanks de verdoving toch voelde. Toen hij de injectie gaf, beet hij me toe dat ik me meer moest ontspannen. Dat lukte dus helemaal niet meer, ik was zo gespannen als een vioolsnaar. Daarna vertelde hij doodleuk dat de naald in mijn oog was blijven zitten omdat ik zo gespannen was. Hij trok de naald eruit en keek niet meer naar me om. Ik was zo flabbergasted dat ik alleen maar weg wilde.
Ik heb daarna te kennen gegeven dat ik niet meer door deze arts behandeld wil worden. Het bleek dat meer mensen hem een hurk vonden. Hij werkt nu niet meer in dat ziekenhuis. Helaas zijn er meer artsen zoals hij, goed in hun vak, maar horken als mens.